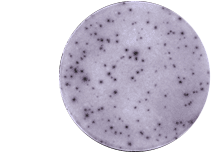
ELISpot-assays-2

ELISpot and FluoroSpot: Antigen Specific Response Assays
Evaluating cell-mediated immune responses
We support global preclinical research with FluoroSpot and ELISpot testing—measuring cytokine-secreting cells at the single-cell level
ELISpot assays
ELISpot assays provide robust measurement of cytokine-secreting cells at the single cell level. Like an ELISA, antibodies for the target cytokine are coated onto a 96-well plate. The cells being assessed are cultured in the same wells, stimulated to release cytokine, and then removed. Bound cytokines are visualized as with an ELISA, using chemiluminescence, with each spot corresponding to a single secreting cell.

FluoroSpot assays
FluoroSpot assays are similar to ELISpot assays but rely on detection using fluorescently labeled detection antibodies.
Fluorescent detection enables simultaneous measurement of cells secreting different cytokines through multiplexing.
Example ELISpot assay panels
| Stimuli | Cell Type Simulated | Details | Stimulates Secretion of Human |
|---|---|---|---|
| CEF peptide pool | CD8+ T cells | Ag-specific stimulation by T cell epitopes derived from CMV, EBV, and influenza | IFN-γ, IL-2, Granzyme B, Perforin |
| CEFT peptide pool | CD4+ T cells | Ag-specific stimulation by T cell epitopes derived from CMV, EBV, Tetanus Toxin and influenza | IFN-γ, IL-2, IL-5, IL-13 |
| Anti-CD3 Ab | T cells | Polyclonal T cell activation | IFN-γ, 2, 4, 5, 10, 13, 17A |
| PHA | T cells | Polyclonal T cell activation | IFN-γ, IL-2, 4, 5, 6, 10, 13, 17A, 21, GM-CSF, Granzyme B, Perforin |
| R848 + IL-2 | B cells | Polyclonal B cell activation | IgG, IgA, IgM |
| Anti-CD40 + IL-4 | B cells | Polyclonal B cell activation | IgE |
| LPS | Monocytes/DC | TLR4 agonist | IL,1β, 6, 8, 10, 12, 23, GM-CSF, MIP1β, TNF-α |
| R848 | Monocytes/DC | TLR/8 agonist | IFN-α, IL-1β, 6, 23, GM-CSF, TNF-α |
Choosing the right immune monitoring technology
Understand use cases for cytokine profiling, cell-based immunophenotyping, gene expression, sequencing, circulating tumor markers, and immunohistochemistry and multiplex immunofluorescence.
Integrating biomarker and clinical trial data
To help researchers understand and interpret biomarker assay data in the context of other assays as well as the clinical trial data, Precision provides the option of managing and analyzing data using our proprietary QuartzBio Translational Informatics platform.
Learn more about the sample management, informatics, and computational capabilities of QuartzBio.
Global reach, multi-site support
Our FluoroSpot and ELISpot testing services support pre-clinical and clinical research, including multi-site studies, conducted anywhere in the world.
Working with Precision
Precision’s specialty lab scientists take a collaborative and consultative approach to projects and can provide recommendations on biomarker assay strategies and implementation. Services can be provided individually or as part of a comprehensive therapeutic development package including biomarker assays and clinical trials.
Additional lab services
-
Explore


Flow Cytometry
ExploreStandard and spectral flow cytometry, on both research-grade and CLIA-validated instruments
Flow Cytometry
ExploreStandard and spectral flow cytometry, on both research-grade and CLIA-validated instruments -
Explore


Epiontis ID® Epigenetic Cell Profiling
ExplorePrecision’s proprietary immune monitoring technology which delivers robust, repeatable, and cost-effective immune cell phenotyping on any sample type
Epiontis ID® Epigenetic Cell Profiling
ExplorePrecision’s proprietary immune monitoring technology which delivers robust, repeatable, and cost-effective immune cell phenotyping on any sample type -
Explore


Cytokine Profiling & Proteomics
ExploreCustomized assays to detect cytokines or proteins of interest utilizing ELISA, Luminex, MSD, SIMOA, and Western Blotting

Cytokine Profiling & Proteomics
ExploreCustomized assays to detect cytokines or proteins of interest utilizing ELISA, Luminex, MSD, SIMOA, and Western Blotting
Explore other related resources
Explore all resources


